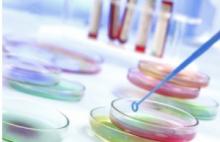

Vous recherchez une actualité
Actualités
Mode d'affichage :
-
PRÉÉCLAMPSIE: Les promesses de l'antidiabétique metformine
Actualité publiée il y a 10 années 2 moise-CIGARETTE: Ses saveurs bonbon font fondre les adolescents
Actualité publiée il y a 10 années 2 mois
-
OBÉSITÉ: Une hormone naturelle pour contrer le cancer du côlon
Actualité publiée il y a 10 années 2 moisEPILEPSIE réfractaire: Le cannabidiol confirme ses promesses chez l'Enfant
Actualité publiée il y a 10 années 2 mois
-
AUDITION: L'écoute intensive de musique amplifiée multipliée par 3 en 10 ans
Actualité publiée il y a 10 années 2 moisSOINS de PLAIES: La pratique de l'exercice accélère aussi la cicatrisation
Actualité publiée il y a 10 années 2 mois
-
OBÉSITÉ: Jusqu'à 26% de la prise de poids liés aux stimuli visuels et publicitaires
Actualité publiée il y a 10 années 2 moisGRIPPE: Avec l'œstrogène, les femmes ont leur antiviral naturel
Actualité publiée il y a 10 années 2 mois
-
CICATRISATION des PLAIES: Tester l'efficacité des thérapies combinées
Actualité publiée il y a 10 années 2 moisGROSSESSE: Equilibrer les apports d'omega pour l'équilibre mental de l'enfant
Actualité publiée il y a 10 années 2 mois
-
CANCER: Découverte d'un suppresseur de tumeur puissant et prometteur
Actualité publiée il y a 10 années 2 moisCANCER de l'OVAIRE: Les sels d'or contre l'arthrite agissent aussi contre la tumeur
Actualité publiée il y a 10 années 2 mois
-
SOIN de PLAIE: Pouvoir prévoir les plaies à cicatrisation retardée
Actualité publiée il y a 10 années 2 moisNEURO: La lecture rapide? Des méthodes à l'efficacité mitigée
Actualité publiée il y a 10 années 2 mois
-
SOMMEIL: Dîner léger pour un sommeil lourd
Actualité publiée il y a 10 années 2 moisÉMOTIONS NÉGATIVES: Oui, le cerveau peut être entraîné à les ignorer
Actualité publiée il y a 10 années 3 mois
-
DYSFONCTION ÉRECTILE: Manger des fruits et faire de l'exercice
Actualité publiée il y a 10 années 3 moisAVC: Vite redonner avec un masque, de l'oxygène au cerveau
Actualité publiée il y a 10 années 3 mois
-
MALADIES liées à l'X: Pourquoi l'un parle et l'autre pas
Actualité publiée il y a 10 années 3 moisDIABÈTE gestationnel: Pas trop de pommes de terre avant la grossesse!
Actualité publiée il y a 10 années 3 mois
-
AUTISME: Un nouveau biomarqueur enfoui dans un pli du cortex
Actualité publiée il y a 10 années 3 moisCERVEAU: L'horloge neurale qui rythme notre vie quotidienne
Actualité publiée il y a 10 années 3 mois
-
ESSAI CLINIQUE: Hospitalisation de 6 patients dont un en état critique
Actualité publiée il y a 10 années 3 moisPrEP vs VIH: La meilleure prévention pour les HSH à risque élevé
Actualité publiée il y a 10 années 3 mois
-
PERTE de POIDS: La restriction calorique envoie des signaux antidiabétiques
Actualité publiée il y a 10 années 3 moisAVC: 73% des jeunes adultes en ignorent encore les signes
Actualité publiée il y a 10 années 3 mois
-
LOMBALGIE: Faire de l'exercice, le moyen le plus efficace pour conjurer le mal de dos
Actualité publiée il y a 10 années 3 moisCHICHA: Un booster de substances toxiques du tabac
Actualité publiée il y a 10 années 3 mois
-
COMPLÉMENTS MINCEUR: Quand le chrome devient cancérigène
Actualité publiée il y a 10 années 3 moisBOISSONS SUCRÉES: Elles favorisent le développement de la graisse viscérale
Actualité publiée il y a 10 années 3 mois
-
CICATRISATION: Séquencer le génome des plaies pour des soins personnalisés
Actualité publiée il y a 10 années 3 moisAPNÉE: Des statines en prévention primaire du risque cardiaque?
Actualité publiée il y a 10 années 3 mois
-
ANALYSE des GAZ du SANG: Un micro-mode capable d'analyser des prélèvements capillaires délicats
Actualité publiée il y a 10 années 3 moisPERTE de POIDS: Optez pour de petites assiettes
Actualité publiée il y a 10 années 3 mois
Pages